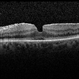

-
000---thumb.jpg/image-square;max$48,0.ImageHandler) By Young Hee Yoon, MD, PhD
By Young Hee Yoon, MD, PhD
Asan Medical Center
Co-author(s): Hye rin Jeong, University of Ulsan, Asan Medical Center - Uploaded on Oct 7, 2012.
- Last modified by Jennifer Hicks on Oct 8, 2012.
- Rating
- Appears in
- Miscellaneous
- Condition/keywords
- intraocular lens dislocation
- Photographer
- Yoon-hwa Kim, Asan Medical Center
- Imaging device
-
Fundus camera
Optomap, optos - Description
- Fundus photograph of an 70-year-old man with a history of cataract operation 20 years ago. He visited our clinic with decreased visual acuity for 2 days.


 Initializing download.
Initializing download.